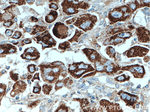
SLC9A9 Antibody in Immunohistochemistry (Paraffin) (IHC (P))
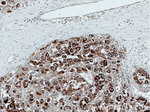
SLC9A9 Antibody in Immunohistochemistry (Paraffin) (IHC (P))

Search
Proteintech
SLC9A9 Monoclonal Antibody (1B8D9)
{{$productOrderCtrl.translations['antibody.pdp.commerceCard.promotion.promotions']}}
{{$productOrderCtrl.translations['antibody.pdp.commerceCard.promotion.viewpromo']}}
{{$productOrderCtrl.translations['antibody.pdp.commerceCard.promotion.promocode']}}: {{promo.promoCode}} {{promo.promoTitle}} {{promo.promoDescription}}. {{$productOrderCtrl.translations['antibody.pdp.commerceCard.promotion.learnmore']}}
产品信息
66577-1-IG
种属反应
宿主/亚型
分类
类型
克隆号
抗原
偶联物
形式
浓度
规格
纯化类型
保存液
内含物
保存条件
运输条件
产品详细信息
Immunogen sequence: TPMLTWLQI RVGVDLDENL KEDPSSQHQE ANNLDKNMTK AESARLFRMW YSFDHKYLKP ILTHSGPPLT TTLPEWCGPI SRLLTSPQAY GEQLKEDDVE CIVNQDELAI NYQEQASSPC SPPARLGLDQ KASPQTPGKE NIYEGDLGLG GYELKLEQTL GQSQLN (481-645 aa encoded by BC035779)
靶标信息
This gene encodes a sodium hydrogen exchanger that is a member of the solute carrier 9 protein family. The encoded protein localizes the to the late recycling endosomes and may play an important role in maintaining cation homeostasis. Defects in this gene are associated with attention-deficit/hyperactivity disorder.
仅用于科研。不用于诊断过程。未经明确授权不得转售。
篇参考文献 (0)
生物信息学
蛋白别名: FLJ35613; Na(+)/H(+) exchanger 9; NHE-9; putative protein product of Nbla00118; Sodium/hydrogen exchanger; Sodium/hydrogen exchanger 9; sodium/proton exchanger NHE9; solute carrier family 9 (sodium/hydrogen exchanger); solute carrier family 9 (sodium/hydrogen exchanger), isoform 9; Solute carrier family 9 member 9; solute carrier family 9, subfamily A (NHE9, cation proton antiporter 9), member 9; unnamed protein product
基因别名: 5730527A11Rik; 9930105B05; AI854429; AUTS16; Nbla00118; NHE9; RGD1560736; SLC9A9
UniProt ID: (Human) Q8IVB4, (Rat) D4A7H1, (Mouse) Q8BZ00
Entrez Gene ID: (Human) 285195, (Rat) 363115, (Mouse) 331004